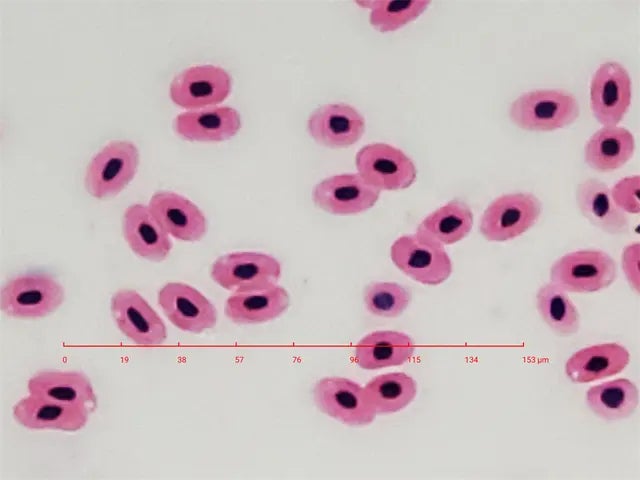

さらなるミクロ世界へ

スマホ顕微鏡の限界に挑戦、驚異の高倍率&高解像度を実現!

多くのユーザーに愛されているミクロハンターシリーズ。そのシリーズ史上、最大倍率の「MH-X250」がこの度登場しました!
観察倍率はなんと最大1200倍。「スマホにここまでできるようになるのか!」と驚異を感じる革新的な顕微鏡レンズです。

(雌の蚊の口:標本)

(ホウライシダの胞子)
レンズ装着はとっても簡単!ピタッと張り付けるだけ!

MH-X250で撮影したミクロの世界をご覧ください。
 (ツユクサの気孔:標本)
(ツユクサの気孔:標本)
(カエルの血液:標本)
(カエルの血液:標本)
 (ハエの口:標本)
(ハエの口:標本)
 (スマホのディスプレイ)
(スマホのディスプレイ)
 (ICチップ:緑の線の太さは1ミクロン)
(ICチップ:緑の線の太さは1ミクロン)
 (ユリの花粉)
(ユリの花粉)
▼玉ねぎの皮の観察動画(29秒)
▼精子の塗抹標本の観察動画(32秒)
▼蚊の観察動画(50秒)


ミクロハンターレンズは、モバイル顕微鏡の常識を打ち破るレンズです。卓上顕微鏡にも匹敵する解像度・光学性能を備えており、財布に入るほどコンパクト。
シリーズ累計で、これまで世界70ヵ国以上の人々に約5万個もの数が提供されてきました(2022年12月時点)。これは携帯型顕微鏡の中でも記録的な数字です。

※2022ベスト・インベンション で「A Smartphone Microscope」と題して紹介されています。

※2023年にTBSのザタイムで「話題のスマホレンズ」として全国ニュースになりました。

もしどこでも気軽にミクロの世界を覗き見る事ができたら、あなたは何を見てみたいですか?子どもに何を見せてあげたいですか?

ぜひ神秘と感動を子どもたちと一緒に味わって頂きたいです。肉眼では見ることのできない世界にきっと目が輝くはず!
財布に忍ばせておき、使いたいときにサッと取り出せる。ミクロの世界を身近にできる秘密道具、「ミクロハンターレンズ」の新製品をご紹介します!


新たに加わったMH-X250はミクロハンターシリーズ史上、最高倍率のスマホ用光学顕微鏡レンズになります。

【ミクロハンターキットX250の内容品】
・microHunter MH-X250
・フォーカススタンド
・専用ケース


▶▶▶特徴① 超高倍率◀◀◀

(Samsung Galaxy S10eに装着&撮影)
MH-X250は、MH-X100よりも倍率が格段に向上しまし、最大1200倍率での顕微鏡観察が可能です。モバイル顕微鏡の限界を押し広げ、よりワクワクする顕微鏡体験を提供します。
▶特徴② 圧倒的な携帯性◀

レンズ単体の重さはなんと0.5g以下。圧倒的な携帯性を誇る、指先サイズの極小顕微鏡レンズです。

またカードサイズの専用ケースには複数のミクロハンターレンズ、マイクロ定規、フォーカススタンドを収納でき、財布に収納可能です。
この圧倒的に優れた携帯性のゆえ、財布やバッグに常に忍ばせておいても邪魔にならず、思いたった時に使用できるのもミクロハンターのおすすめできる点です。
▶特徴③ 使い方簡単◀

スマホへの装着はとても簡単! 装着後は、見たいものに近づけるだけ(高倍率なのでフォーカススタンドでピント固定する事をおすすめします)。お手軽にミクロの世界を楽しんで下さい♪
詳しい使い方は以下のURLから!
https://microhunter.karaseed.com/manual/
▶▶▶特徴④ 優れたレンズ設計◀◀◀

多非球面レンズ採用により歪みを極限まで抑えた高度なレンズ設計。
顕微鏡において、このレンズ構成は非常に重要な要素です。像面湾曲、球面収差、その他の収差を解消することでピントの合う視野が広くなります。ミクロハンターレンズは高解像度と低収差の両方を実現した顕微鏡レンズです。
この光学性能試験からわかる通り、MH-X250 は卓上顕微鏡に匹敵する優れた光学性能を備えています。

上の画像はMH-X250 と卓上顕微鏡(MoticDMB-1223)の比較です。植物の茎の断面を映したものですが、光学性能の素晴らしさがわかります。
▶▶▶特徴⑤ 高解像度◀◀◀

MH-X250は約0.7ミクロンというサブミクロン(1万分の1ミリ)レベルの高解像度を達成しました。

▶▶▶特徴⑥ 正確なフォーカス操作◀◀◀
セットに付属のフォーカススタンドを利用すると簡単にピント合わせ、ピントの固定が可能です。

▶▶▶特徴⑦ 高い汎用性◀◀◀

ミクロハンターレンズ はあらゆるカメラ付きスマホで使えるように設計されています。 マルチカメラ搭載機種はもちろん、ケースを付けていても使用可能です。
※詳しくは「よくある質問」を要確認
※撮影中にもライトをONにできるカメラアプリの使用をおすすめします。
▶▶▶特徴⑧ 革新的なナノパッド◀◀◀

独自開発した吸着ナノパッドにより、簡単にスマホに取り付け可能。レンズを傷付ける心配はありません。
吸着が弱くなったら、マスキングテープなどの弱粘着性テープで汚れや油脂を取り除くことで吸着力を復活させることが可能でき、何度も着脱可能です。
▶▶▶特徴⑨ 革新的な照明設計◀◀◀

多くのスマホにはライト機能がついています。ミクロハンターレンズ には革新的な透過光設計を取り入れられ、スマホライトで明るく撮影できます。

専用ケースも照明ボックスとして役立ちます。スマホライトや周囲光は、サンプルを直接照らすだけでなく、ケースの底面からの反射光もサンプルを照らします。
▶▶▶レンズ比較◀◀◀
ミクロハンターレンズは今回の新製品も含め全4種類あります。それぞれの違いについては以下の表をご参照ください。

(レンズ4種類すべて購入をご希望の方は、「レンズ4種セット」のリターンを選択して下さい。)


対物レンズと接眼レンズを組み合わせた光学顕微鏡とは違い、ミクロハンターレンズは3段階の倍率を組み合わせて高倍率を実現しています。

これにより最大1200倍もの倍率を可能に。光学技術とスマートフォン技術の進歩、そして過去数年間に蓄積された努力と専門知識により、ミクロハンターレンズ は優れたコストパフォーマンスを達成しています。

持ち運びに便利で、複雑な設定も必要ないので、様々なシーンで利用可能。また画像をすぐに共有することもできます。

自然は感動と好奇心を揺さぶる存在の宝庫です。素晴らしいミクロの世界を子どもたちと一緒に探索し、楽しみながら子供たちの好奇心を育てる事ができます。また、ミクロハンターはミクロの世界を楽しむだけではなく、その性能の高さから多くの職業の現場でも役立つ製品です。


ミクロハンターレンズは、撮影中もライトをONにできるカメラアプリが入っていればどんなスマホでも使用可能です。記録として顕微鏡写真にスケールバーを表示させたい場合は、専用アプリの「i-Seeing」をダウンロードして下さい。専門家のニーズを満たす顕微鏡写真を撮影できるように設計されています。

スケールバー表示のオン/オフ切り替えが可能。Androidアプリ、iOSアプリの両方に対応しています。※スマホの種類、OSバージョンによってうまく動作しない場合がございます
その他おすすめのカメラアプリについては、製品公式サイトの「カメラアプリについて」をご覧ください。

★使い方概要動画
★詳しい使い方や注意点
製品公式ページの「使い方」をご覧ください。
▶機能一覧◀
ミクロハンターレンズは優秀な光学性能に加え、他にも様々な優位性をもった顕微鏡レンズです。



開発者である「Shanghai Qingying E&T LLC」は顕微鏡写真を楽しんだり、ミクロの世界を探索したりするための新しい顕微鏡ツールを開発・提供することを目的とした企業です。
2012年に最初の製品を世に送り出して以来、スマホの顕微鏡ツールの開発には長い道のりを歩んできました。製品ユーザーの提案や感想に耳を傾け、ミクロハンターレンズ のアイデアを形作り、磨き上げました。 度重なる試作品の製作、試験、改良を繰り返し、コストパフォーマンスの非常に高いマイクロレンズを製造しています。
ミクロハンターレンズの誕生は、リー・キュイというひとりの人の情熱から始まりました。子ども時代、学校の理科の授業をきっかけにミクロの世界に魅了されたリー・キュイ。しかし、当時リーの家族には経済的な余裕がなく、高額な顕微鏡を買ってもらう事できなかったという経験がありました。ミクロの世界への情熱は大学卒業後も消えることはなく、電子産業に就職。そこで最先端の光学技術を学び、様々な研究に携わりました。その後、「誰もが気軽に買えて気軽に使える高性能な顕微鏡をつくろう」という信念をもと、優れた電子技術や光学技術を持つ仲間たちを結集し、2012年に「Shanghai Qingying E&T LLC」を設立しました。

現在公式ショップで販売中のミクロハンターシリーズをご使用されているお客様からの声です。

実は、あの珪藻標本作家の奥修様からも評価を頂いています。
「スマホ用のレンズは数々ありますが、像品質は群を抜いているように見えます。珪藻を撮影しているので筆者には性能が一目でわかります。像品質もよく、球面収差は小さめです。顕微鏡を使わずにスマホにレンズ一個つけただけでということを考えると、この画質と解像はほとんど”驚異的”といってよろしいかと思います。」
(ミクロワールドサービス代表 奥修 様)
▶仕様◀
・サイズ(レンズ本体):12.7×3.4mm
・サイズ(ケース収納時):60×90×5mm
・商品の製造国:中国(上海)
・商品の素材:PC
・保証期間:1年間
▶FAQ◀
Q.ケースを付けたままでも使用できますか?
A.レンズの直径が12.7mm、吸着パッドの直径が10mm(厚み0.4mm)です。レンズ取り付け部にその分のスペースがあればスマホケースをつけたままでもレンズを取り付け可能です。

Q.吸着パッドはどのような面にくっつきますか?
A.旧略パッドは、つるつると滑らか、かつ平らな表面でしっかりとくっつきます。多孔質な表面や凹凸のある表面ではうまく吸着しません。
Q.吸着パッドは使っているうちに吸着力は落ちてきますか?
A.使用しているうちにホコリや汚れがついて吸着力は落ちてきます。吸着力が落ちてきたらマスキングテープなどの弱粘着テープで汚れを取り除き吸着力を復活させることができます。
Q.所有しているスマホには複数レンズがありますが、使えますか?
A.標準レンズ(広角レンズ)や望遠レンズに装着して使えます。超広角レンズはケラレてしまうのでおすすめしません。マニュアルでレンズの切り替えを行えるカメラアプリがあると便利です。おすすめのカメラアプリについては、製品公式サイトの「カメラアプリについて」をご覧ください。
Q.最近のスマホのレンズは大きいですが、対応していますか?
A.標準レンズ(広角レンズ)や望遠レンズであれば、使用可能です(超広角レンズは使用不可)。
Q.持っているスマホでは撮影中ライトが点灯できませんが使えますか?
A.お使いのカメラアプリによっては撮影中にライトを点灯できない場合があります。その場合は別にアプリをダウンロードして下さい。すでにお持ちのアプリでも、動画だと撮影中もライトを点灯できる場合もございます。おすすめのカメラアプリについては、製品公式サイトの「カメラアプリについて」をご覧ください。
Q.レンズは水に濡らしても大丈夫ですか?
A.多少濡れても大丈夫ですが、レンズを水にさらす事はおすすめできません。レンズが濡れた場合はしっかりと自然乾燥させてください。
Q.専用アプリi-Seeingは定期的にアップデートされますか?
A.アプリは必要に応じてアップデートされています。ただし、Andoroid版アプリについては、Androidスマホの機種が多すぎるためすべてのスマホに対応する事は難しく、お持ちの機種によってはうまく動かないことがあります。iOS版は動作が比較的安定しています。
※その他ご使用に関するご質問は「よくあるご質問」をご確認ください
※また公式LINEでも質問を受け付けていますので、お気軽にお問い合わせ下さい。
▶スケジュール◀
10月22日 プロジェクト開始
11月下旬 工場に発注
12月10日 プロジェクト終了
1月中旬 配送手配
※輸送状況や通関状況により配送手配が遅れる場合がございます。遅くても2月中には配送できるように尽力致します。
▶リターンについて◀


※複数のリターンをまとめて購入する事もできますので、入力画面のメッセージに従って操作して下さい。
※付属品について、詳しくは以下をご覧ください
▶付属品の説明◀
※付属品はセットによって異なります。どの品物が付属するかは、リターン詳細をご確認ください。

※詳しい情報は製品公式ページの「マイクロ定規&マイクロチャート」をご確認ください。

※詳しい情報は製品公式ページの「マイクロ定規&マイクロチャート」をご確認ください。





(※岩石薄片プレパラートと放散虫標本はリターンメニューにはございません。公式ショップよりお買い求めください。)
▶実行者紹介◀

合同会社KaraSeedはミクロハンター(microHunter)の総代理店(正規代理店)です。物販をグローバルに事業展開し、「モノ・コトを通してお客様の人生を豊かにする」ことを目指している会社です。
その思いに沿って厳選した製品を、必要とするお客様に届ける、それが私たちのパッションです。製品に込められた作り手の思い、それを使うお客様の思いを大切に、活動しています(Webサイト:https://www.karaseed.com/)。
※ミクロハンター製品に関するご質問は公式LINEにて受け付けていますので、お気軽にお問い合わせ下さい。
▶資金の使い道について◀
集まった資金は以下の目的のために使用させて頂きます。
・広報費
・プロダクトの仕入費
・発送費
▶製品メーカーについて◀
・メーカー名:Shanghai Qingying E&T LLC
・ウェブサイト:https://www.mobile-scope.com/
・事業内容:顕微鏡製品の開発
▶特定商取引法に関する記載◀
●販売事業者名合同会社KaraSeed
●代表者または通信販売に関する業務の責任者の氏名請求があり次第提供致しますので、必要な方はメッセージ機能にてご連絡ください。
●事業者の住所/所在地〒183-0011 東京都府中市白糸台4-2-8
●事業者の連絡先請求があり次第提供致しますので、必要な方はメッセージ機能にてご連絡ください。
●リターン価格各リターン記載の通り※ 商品内容に関してはリターン欄記載の通り※リターン価格とは別にCAMPFIREのシステム利用料として、支援金額1万円未満の場合は250円(税込)/ 1万円以上の場合は支援額の2.5%(税込)が支援者様の負担となります。※上記システム利用料はCAMPFIREが受け取るもので、当社が受領するものではございません。
●送料送料込み
●対価以外に必要な費用プロジェクトページ、リターンに記載のとおり。
●支払い方法CAMPFIREの決済手段に準ずる (詳細はこちら)
●支払い時期当プロジェクトは「All-in型」の為、目標達成の如何に問わず、ご契約が成立しリターンをお届けします。その為、お申込みと同時にご利用の決済方法に準じてご請求となります。
●引渡し時期各リターン詳細に記載の発送予定月を引き渡し時期とします。但し、開発・生産状況によって遅れが生じる場合がありますのでその際は当プロジェクトページ内の「活動報告」または購入者へのメール等で連絡します。
●キャンセル・返品当プロジェクトは「All-in型」の為、お申込み完了をもって契約が成立いたします。その為、お客様都合による返品・キャンセルはできませんのでご注意ください。尚、製品到着後に破損や初期不良がある場合には交換させていただきますので「メッセージで意見や問い合わせを送る」から、または納品書記載の連絡先までお問い合わせください。
●ソフトウェアに係る取引である場合のソフトウェアの動作環境該当なし
●取扱説明書の有無パッケージのQRコードを読み込むと日本語の使用説明サイトにアクセスできます。
●その他記載事項プロジェクトページ、リターン記載欄、共通記載欄(https://camp-fire.jp/legal)をご確認ください。
※上記以外の事項に関しては、お取引の際に請求があれば遅延なく提示いたします。
<募集方式について>
本プロジェクトはAll-in方式で実施します。目標金額に満たない場合も、計画を実行し、リターンをお届けします。
最新の活動報告
もっと見る
新製品・スマホ用高倍率偏光顕微鏡レンズ(光学250倍)【MH-X250P】の先行販売開始
2026/04/01 17:10こんにちは!ミクロハンターです。多くの方からご要望を頂いていた高倍率偏光顕微鏡レンズ(光学250倍)【MH-X250P】が、本日machi-yaにて先行販売を開始しました。販売ページ:https://camp-fire.jp/projects/929486/view※この期間限定、お得なレンズ5種キットも販売中です「より高倍率で偏光顕微鏡観察を楽しみたい」「特殊観察による不思議なミクロの世界を見てみたい」MH-X250Pは、そんな方たちにぜひおすすめしたいです。(上画像:長芋の針状結晶。長芋を塗りつけて観察。)(上画像:ジャガイモのでんぷん粒。ジャガイモを塗りつけて観察。)\MH-X250Pの特徴/①高倍率観察(光学250倍)②偏光を利用した特殊観察③高度なレンズ設計による高解像度④財布に収納可能な圧倒的な携帯性⑤ほぼ全てのスマホに対応し、機種変更しても使い続けられるなどなど指先サイズ、でも卓上顕微鏡にも劣らない性能を有し、様々な可能性を秘めています。販売ページ:https://camp-fire.jp/projects/929486/view※この期間限定、お得なレンズ5種キットも販売中ですミクロハンターは基本的には先行販売期間中しか割引を行わないため、ぜひこのチャンスをご検討ください。 もっと見る
ミクロハンターレンズのピント合わせの課題を解決する新製品
2025/04/15 17:56こんにちは!ミクロハンターです。本日は皆様のお役に立つ情報です。お客様から「ピント合わせが難しい」という声がよく聞かれていましたが、この声をもとにピント合わせの補助用品を開発しました!観察対象との距離をダイヤル操作で細かく調整できるため、ピント合わせが格段にラクになりますまた、なんとタブレットでの顕微鏡観察も可能に!販売ページ:https://microhunter.shop/products/mh-fs02※留意点はご一読ください▼セット内容▼スマホで観察する様子▼製品の特長 ・ツマミを回すだけでピント調整が簡単・スムーズ ・組み立て式スタンドよりも直感的に使える操作性 ・滑り止めがついており操作中にスマホがずれにくい ・スマホだけでなく、10インチ以内のタブレットであればミクロハンターレンズの使用が可能に ▼使用者様のご感想▼販売ページhttps://microhunter.shop/products/mh-fs02※留意点はご一読ください もっと見る
【ミクロハンター】新レンズMH-X250の一般販売開始!
2025/02/04 19:30\新レンズMH-X250の一般販売開始!/大変お待たせしました!ミクロハンターレンズ史上、最大倍率を誇るMH-X250のキット「ミクロハンターキットX250」の一般販売を開始しました。一般販売についてたくさんのお問い合わせを頂いておりましたが、開始までお時間がかかってしまった事、申し訳ございません!このレンズMH-X250はスマホ機能と合わせて250~1200倍での観察が可能で、生物や植物の組織、微生物を観察するのに向いています。これまでのレンズでは観察できなかったミクロ世界を探索する事ができますので、ぜひ色々と観察してみてください。公式ショップにてご購入可能です。https://microhunter.shop/products/kit-x250※現在の在庫が売り切れた場合は、入荷にお時間頂く場合もございます。 もっと見る















支援を検討中ですが、領収書の発行は可能でしょうか?
基本的な質問で恐縮ですが、このレンズは顕微鏡画像をアプリとスマホのカメラを連動して写真や動画を記録できるのでしょうか?